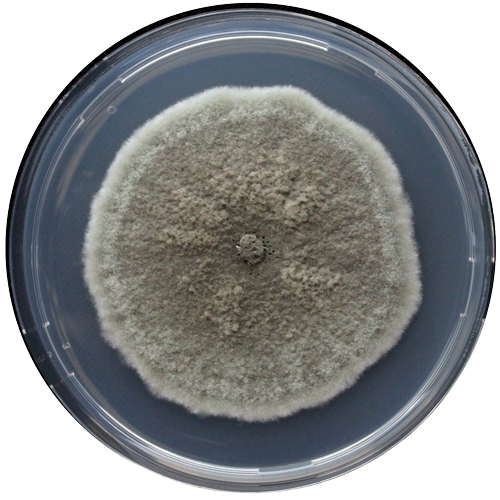

$97.298 más I.V.A.
RGM 2579
Categoría:
Género:
Alternaria
Especie:
tenuissima
Cepa tipo:
No
Código de otra colección:
15MC
Fecha de aislamiento:
2015
País de origen:
Chile
Historial de deposito:
Instituto de Investigaciones Agropecuarias (INIA)<-Pontificia Universidad Católica de Chile (PUC)
Sustrato de origen:
Fruto (Manzana corazón pardo, cultivar Red Chief)
Acceso GenBank:
MG925193 (AltA1)/MG740646 (ATPasa)/MG925151 (CAL)
Temperatura óptima de crecimiento:
25º
Regiónalizas secuenciada:
Alternaria major allergen A1 /Plasma membrane ATPasa/ Calmodulina
Medio de cultivo:
Agar papa dextrosa
Nivel de riesgo:
Restricciones de distribución:
Sin restricción de distribución
Información adicional:
https://doi.org/10.1094/PDIS-02-18-0282-RE
Fecha de subida al catálogo:
Secuencias nucleotídicas:
Otros comentarios: